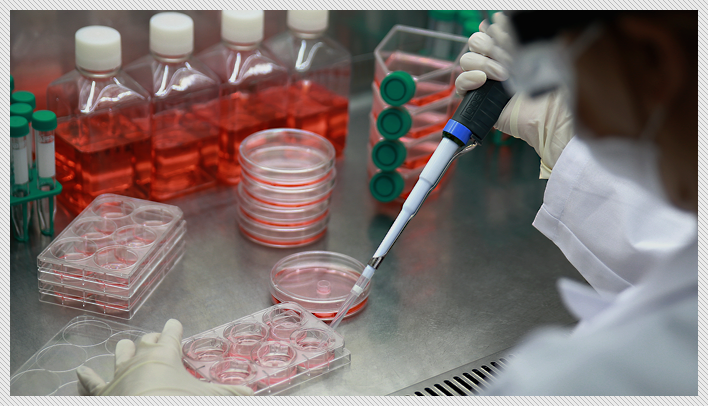

|
PAKISTAN HOSPITAL
|
Serving Science With Passion |

 |
PAKISTAN HOSPITAL
|
Serving Science With Passion |

Pakistan Hospital & Industrial Laboratory Company (PHILCO) welcomes our customers to get in touch with us if they are interested in mentioned services.